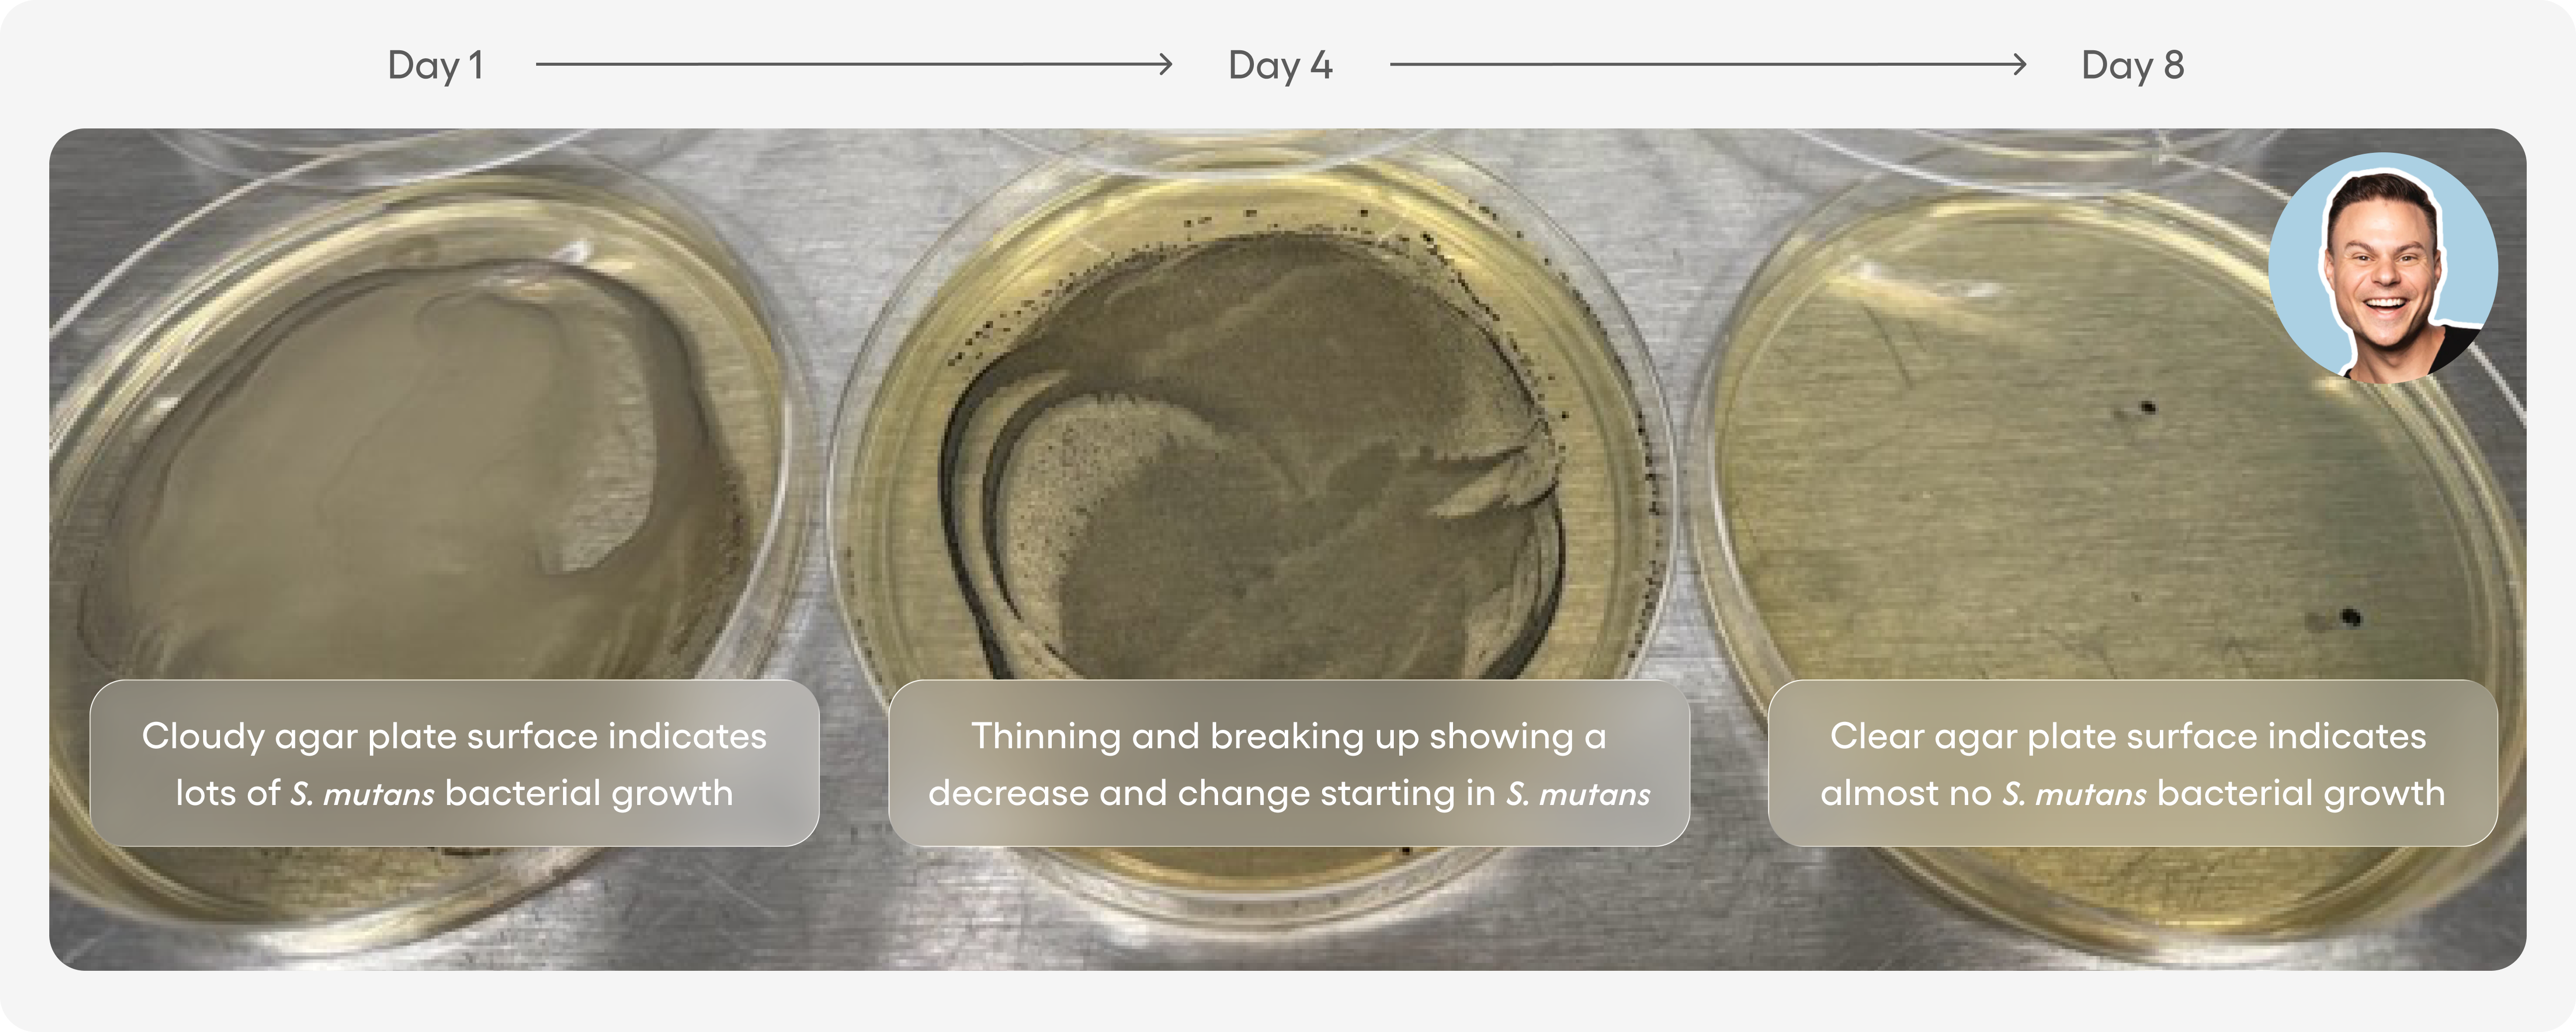

300,000+ smiles & counting
Oral care you can chew.
Halo™ is like a supplement for your smile—designed to support your mouth between brushings by remineralizing and ensuring harmful bacteria never get the upper hand.
300,000+ smiles & counting
Oral care you can chew.
Halo™ is like a supplement for your smile—designed to support your mouth between brushings by remineralizing and ensuring harmful bacteria never get the upper hand.
Limited launch offer on now!
A Healthier Smile With Every Chew

Natural Chicle Base

No Plastics or Rubber

No Aspartame or Sucralose

BioFuse™ Oil Matrix

With nHAp & Xylitol

No Artificial Flavors










Why Halo Gum?
Halo™ is advanced gum that fights bad bacteria, promotes remineralization, and freshens your breath while you chew. Halo isn't like the gum you're used to. It contains a natural chicle base, natural sweeteners, and natural flavors, along with advanced biotech ingredients like BioFuse™ Oil Matrix, nano-hydroxyapatite, and xylitol. Importantly, Halo™ is formulated without aspartame, artificial plastics, and rubbers.
Ingredients
Xylitol, Gum Base (Chicle), Nano-Hydroxyapatite, Natural Flavors, Flaxseed Oil, Rosehip Oil, Stevia, Menthol, Spearmint Oil, Peppermint Essential Oil
Directions
Chew 1-3 pieces per day after meals, coffee, or acidic beverages, for at least 15 minutes or as long as desired.
One pack should last for one week. A four-pack is approximately a 30-day supply if you chew 2 pieces per day.
Benefits
Results may vary, but users report increased saliva flow, a cleaner-feeling mouth and smoother teeth up to 90 minutes after chewing their first piece. Over time, the BioFuse™ Oil Matrix, nHAp, and Xylitol will reduce harmful microbiome, remineralize damaged enamel, and keep cavities at bay.
Halo™ Advanced Gum
New!
BioFuse™ Oil Matrix
With nHAp
Choose Your Offer:
Subscribe & Save
Extra 10% OFF first subscription order
BLACK FRIDAY
Up to 33% Off
Easily customize your plan, your frequency, cancel or skip a single item in your delivery. You’re in control.
2 Pack
2-week supply
$0.67 per piece
20% OFF
best value
4 Pack
4-week supply
$0.57 per piece
25% OFF
Free Shipping
8 Pack
8-week supply
$0.50 per piece
32% OFF

20% off recurring orders

Earn points towards rewards

Fast Delivery

Change, pause, or cancel
One-time purchase
$29.99
2 Pack
2-week supply
$0.83 per piece
$29.99
Save

No 25% off extra discount

No rewards points

shop now on Amazon

Made In USA

Free Shipping $60+

30 Day Returns
TRY A STARTER KIT
Why Halo Gum?
Halo™ is advanced gum that fights bad bacteria, promotes remineralization, and freshens your breath while you chew. Halo contains a natural chicle gum base, natural sweeteners, and natural flavors, along with advanced biotech ingredients like BioFuse™ Oil Matrix and nano-hydroxyapatite. Importantly, Halo is formulated without aspartame, artificial plastics, and rubbers.
Ingredients
Xylitol, Gum Base (Chicle), Nano-Hydroxyapatite, Natural Flavors, Flaxseed Oil, Rosehip Oil, Stevia, Menthol, Spearmint Oil, Peppermint Essential Oil
Directions
Chew 1-3 pieces per day after meals and acidic beverages, for at least 30 minutes or as long as desired.
One pack should last for one week. A four-pack is approximately a 30-day supply if you chew 2 pieces per day.
Benefits
Results may vary, but users report increased saliva flow, a cleaner-feeling mouth and smoother teeth up to 90 minutes after chewing their first piece. Over time, the BioFuse™ Oil Matrix, nHAp, and Xylitol will reduce harmful microbiome, remineralize damaged enamel, and keep cavities at bay.
Chewable Oral Care

BioFuse™
🦷
nHAp

Sugar-Free
🌿
Chicle Base

BioFuse™ Oil Matrix
Our unique botanical blend that targets harmful oral microbiome.
🦷
nHAp
A fluoride-alternative and mineral that remineralizes damaged enamel.
🎋
Xylitol
A natural sweetener that fights cavities and boosts beneficial saliva flow.
🌿
Chicle Gum Base
A natural gum base derived from the sapodilla tree.
🌱
Stevia
A natural calorie-free sugar-free sweetener derived from plants.
🍃
Natural Mint Flavors
Menthol, peppermint, and spearmint essential oils help freshen breath.
THE TRUTH ABOUT GUM
Most chewing gums are made with petrochemical rubbers, artificial sweeteners and lab-made flavors. They may taste nice, but you're chewing on a chemical cocktail with no real benefits.
Halo™ was made to be different.
From what it's made with, to what it does, Halo™ delivers what no other gum can claim. Naturally-derived ingredients combine with BioFuse™ Oil Matrix, nHAp and xylitol to battle bad bacteria, refresh, restore, and renew, all while you chew.

BioFuse™ Oil Matrix keeps your mouth protected from the 'bad actors' of the oral microbiome while leaving the good stuff untouched.
SEE THE RESULTS OF BIOFUSE™ OIL MATRIX IN CLINICAL TESTING
Lab Assay Results
99.9% reduction in both bad bacteria during in vitro lab tests versus regular toothpaste.
In just 10 minutes of exposure, BioFuse™ Oil Matrix effectively eliminated both bad bacteria types by 99.9%.

Dr. Winter's Story
Near-complete elimination of harmful S. mutans in saliva after 8 days of brushing.
Dr. Winters tested his own saliva over 8 days while brushing with BioFuse™ Oil Matrix and saw near-complete elimination of S. mutans.
Swipe to see the results!
Clinical Trial
Clinical trial participants brushing with BioFuse™ Oil Matrix had ~50% less bad bacteria after 14 days.
Results of S. mutans in saliva compared to Placebo group who brushed with a major toothpaste brand over the same period.

Testing On Good Bacteria
BioFuse™ Oil Matrix shows selective elimination of bad bacteria, while letting the good guys recover.
Saliva samples collected before and after brushing with BioFuse™ Oil Matrix showed highly selective elimination of only bad bacteria.


WHAT YOU GET WHEN THEY'RE GONE

Less Cavities

Stronger Enamel

Healthier Microbiome

Lower Inflammation

Fresher Breath

Balanced pH

Bone Density Support

Whole-Body Benefits
Chew Smarter, Live Healthier
A new generation of oral care—refreshing, rebuilding, and restoring your smile is easier than ever with Halo™.
Microbiome Balance
BioFuse™ technology removes bad bacteria, keeps the good
Enamel Protection
nHAp remineralizes and strengthens teeth
Cavity Fighting
Xylitol reduces harmful bacteria and promotes saliva
Natural Ingredients
Plant-based base and flavors without rubbers or plastics

Us Vs. Them
Not overhyped or overpriced. Just comprehensive smile care made for everyone.
Clinically-proven ingredients
BioFuse™ Oil Matrix
Remineralizes with nHAp
No plastics, rubbers, or artificial flavors
Fights cavities with Xylitol
Promotes balanced oral pH







Big gum brands






Natural gums






Demand more for your mouth.
We know there's a lot of choices in oral care out there. But we wanted to bring real innovation and purpose into an industry plagued by gimmicks. Here's how Something Nice is putting the care back into smile care.

Created by a real orthodontist

Science-backed, no-gimmick formulas

Solves real-world
oral care problems

Designed to give back to others


Formulated by a dentist, made for you
After seeing the oral care industry stop innovating and continue to push centuries-old formulas, Dr. Winters decided it was time for some real change. With our breakthrough proprietary BioFuse Oil Matrix™ to protect your smile from harmful bacteria, nHAp to rebuild enamel and natural flavors and sweeteners, Halo™ is the most advanced gum ever.
Read Our Story
Traditional oral care built the foundation.
We're building the future.
HERE TO HELP
Have a question?
What is BioFuse Oil Matrix™ and how does it work?
BioFuse™ Oil Matrix is our advanced botanical blend which helps disrupt harmful oral microbiome while leaving the good stuff untouched. Formulated alongside clinical researchers, this botanical blend selectively targets cavity and periodontal disease-causing bacteria, S. mutans and P. gingivalis, and physically destroys the integrity of their cell walls (imagine poking holes in a balloon), effectively killing them.
What is chicle and where does it come from?
Chicle is a gum that consists of the coagulated milky latex of the sapodilla tree, a tropical American fruit tree principally from Yucatán and regions of Central America. It has been chewed for centuries in many cultures and was the original base for gum before the mid-twentieth century use of waxes, plastics, and synthetic rubbers.
*NOTE: Chicle is likely unsafe for individuals with latex allergies. It's derived from the natural latex sap of the Sapodilla tree and contains rubber proteins that can trigger allergic reactions in sensitive individuals—similar to cross-reactions seen with bananas, avocados, or kiwis.
What is nano-hydroxyapatite and why is it included?
Nano-hydroxyapatite (nHAp) is a biocompatible mineral that's identical to what your teeth are naturally made of. Originally developed by NASA to help astronauts with bone density loss, it works to directly rebuild tooth enamel, whereas fluoride just helps your teeth absorb more minerals. nHAp has been shown to be just as effective as fluoride in preventing cavities while reducing sensitivity.
Why do I have so much extra saliva when I chew Halo?
Congratulations! You're experiencing the effects of BioFuse™ Oil Matrix and Xylitol working together to stimulate saliva flow. Not only does this help spread the active ingredients around your mouth, increased saliva production helps with protecting teeth, neutralizing acids, fighting bacteria, and facilitating essential bodily processes.
How often should I chew Halo™?
We recommend chewing 1-3 pieces per day, after meals or acidic beverages, or when you need a boost of freshness or need some dry mouth relief.
One box should last approximately 1 week if you chew 2 pieces per day.
Complete Your Routine
what they’re saying
See the glow from our community































